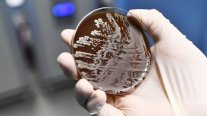
انتظروا ما هو أفظع من كورونا!

باريس: تلقت الولايات المتحدة الجمعة دعماً من إسرائيل فقط في تصويتها ضدّ نصّ في الجمعيّة العامّة للأمم المتّحدة يدعو إلى "استجابة شاملة ومنسّقة" في مواجهة جائحة كوفيد-19 ويتضمن اعترافا بالدور القيادي لمنظمة الصحّة العالميّة في هذا الاطار.
وهذا النصّ الذي تمّ التفاوض بشأنه منذ أيّار/مايو، اعتُمد بغالبيّة ساحقة من جانب 169 دولة من البلدان ال193 الأعضاء الأمم المتحدة، فيما امتنعت أوكرانيا والمجر عن التصويت.
أودى فيروس كورونا المستجدّ بحياة 916,372 شخصا على الأقل في العالم منذ أبلغ مكتب منظمة الصحة العالمية في الصين عن ظهور المرض نهاية كانون الأول/ديسمبر، حسب تعداد وضعته فرانس برس استناداً لمصادر رسميّة حتى الساعة 11,00 ت غ السبت.
وسُجّلت رسميّاً 28,5 مليون إصابة مؤكدة بالفيروس منذ بدء تفشيه.
والولايات المتحدة هي البلد الأكثر تضرراً من حيث عدد الوفيات والإصابات مع تسجيلها 193,016 وفاة من أصل 6,445,800 إصابة حسب تعداد جامعة جونز هوبكنز. وشفي ما لا يقل عن 2,417,878 شخصا.
تخطّت البرازيل الجمعة عتبة 130 ألف وفاة جرّاء كوفيد-19، وسط تفاؤل حذر حيال مؤشرات على تباطؤ انتشار الفيروس في أكثر البلدان تضررا في اميركا الجنوبية.
وبعد أن استمر عداد الوفيات بتسجيل أكثر من ألف وفاة يوميا من حزيران/يونيو الى آب/اغسطس، بدا وأن المؤشر آخذ بالتراجع، اذ بلغ متوسط عدد الوفيات اليومي خلال الأسبوع الماضي 696.
فرضت لاتفيا حجرا صحيا اجباريا لمدة 14 يوما على الوافدين من استونيا المجاورة التي شهدت ارتفاعا كبيرا في عدد الاصابات.
أعلن منظمو طواف فرنسا للدراجات الهوائية عن اجراءات خاصة في ما يخص دخول الجمهور الى نقطتي البداية والنهاية للمراحل الثلاث القادمة التي تجري في مناطق مصنفة "حمراء" لانتشار فيروس كورونا فيها بشكل كبير.
ستخضع وريثة العرش الإسباني الأميرة ليونور إلى الحجر الصحي بعد رصد إصابة أحد زملائها في الدراسة بفيروس كورونا المستجد، وفق ما ذكر مصدر من القصر الملكي.
وقال ناطق باسم القصر لوكالة فرانس برس "بعد اكتشاف إصابة بكوفيد-19 لدى أحد الطلاب في صف أميرة أستورياس، وأوصت المدرسة أولياء الأمور بعدم حضور تلامذة هذا الصف لمدة 14 يوما".
وافق لاعبو رياضة الركبي في بريطانيا على اقتطاع 25 بالمئة من أجورهم لموسم 2020-2021 في الوقت الذي يحاول اتحاد اللعبة الحد من الخسائر المالية الناجمة عن فيروس كورونا.
ومع مراجعة الحكومة لخطط السماح للجمهور بالعودة الى الملاعب في تشرين الاول/اكتوبر بعد ارتفاع في عدد الاصابات في البلاد، فان اللعبة قد تواجه مزيدا من تراجع المداخيل.

التعليقات